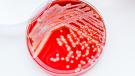

Syndrom toxického šoku
Příznaky toxického šoku:
Horečka
Nízký krevní tlak
Vyrážka
Zvracení
Průjem
Při výskytu těchto příznaků je nutno ihned kontaktovat lékaře.
Zásady prevence při používání menstruačních tamponů:
Důkladné umytí rukou před zaváděním tamponů
Uchovávání tamponů na suchém místě (ne v koupelně či na záchodě)
Používání pouze čistých, důkladně zabalených tamponů
Používání tamponů s nižší absorpční schopností
Střídání používání tamponů s používáním vložek
Pravidelné měnění tamponů
Léčba:
Syndrom může být úspěšně léčen antibiotiky. Šokem však mohou být poškozeny vnitřní orgány, zejména játra a ledviny.
Autor: mk
Komentáře
to se bakterie nestačily pomnožit - to je spíš alergie - v tamponech je plno svinstva
- Pro vkládání komentářů se musíte registrovat nebo přihlásit

- Pro vkládání komentářů se musíte registrovat nebo přihlásit
Pošli odkaz